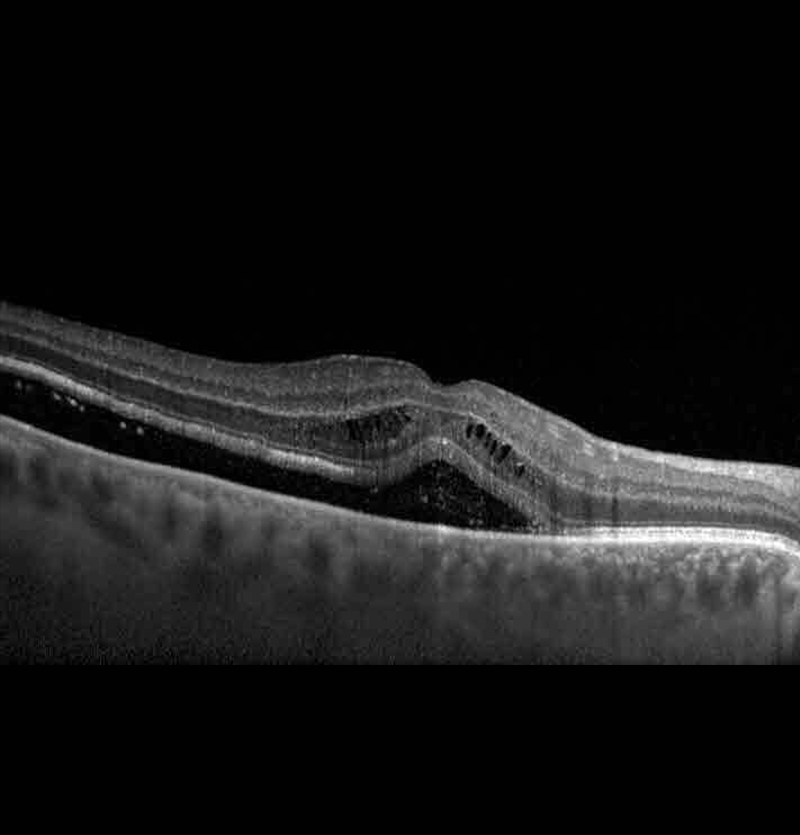
أمراض الشبكية

يمكن إجراء الاختبارات التالية لتحديد موضع المرض ومداه:
- اختبار شبكة آمسلر. قد يستخدم الطبيب شبكة آمسلر لاختبار صفاء رؤيتك المركزية. سيسألك إذا كانت خطوط الشبكة تبدو شاحبة، أو مكسورة، أو مشوهة؛ حيث سيدون مكان حدوث ذلك على الشبكة لتحقيق فهم أفضل لمدى تلف الشبكية. إذا كنت مصابًا بالتنكس البقعي، فقد يُطالبك أيضًا باستخدام هذا الاختبار لمراقبة حالتك ذاتيًا في المنزل.
- التصوير المقطعي للاتساق البصري (OCT). يُعد هذا الاختبار أسلوبًا رائعًا لالتقاط صور دقيقة للشبكية بغرض تشخيص الأغشية فوق الشبكية، والثُّقوب البقعية، والتورّم البُقعي (الوذمة)، ومراقبة مدى الانحلال البقعي السلي المرتبط بتقدم السن، ومراقبة الاستجابات نحو العلاج.
- التصوير الوعائي الصبغي بالفلورسين. يستخدم هذا الاختبار صبغة تتسبب في ظهور الأوعية الدموية الموجودة في الشبكية تحت ضوء خاص. يساعد ذلك في تحديد الأوعية الدموية المغلقة، وتسربات الأوعية الدموية، والأوعية الدموية غير الطبيعية، والتغيرات الدقيقة في خلفية العين.
- تصوير الأوعية الدموية باستخدام صبغة الإندوسيانين الأخضر. يستخدم هذا الاختبار صبغة تضيء عند تعرضها للأشعة تحت الحمراء. تُبين الصور الناتجة الأوعية الدموية للشبكية والأوعية الدموية العميقة الواقعة خلف الشبكية في نسيج يسمى بالمشيمية والتي يصعب رؤيتها.
- الموجات فوق الصوتية. يستخدم هذا الاختبار موجات صوتية عالية التردد (التصوير بالموجات فوق الصوتية) للمساعدة في استعراض الشبكية والبنيات الأخرى الموجودة في العين. كما يمكنه تحديد سمات النسيج المحددة والتي يمكنها المساعدة في تشخيص أورام العين وعلاجها.
- التصوير المقطعي المحوسب (CT) والتصوير بالرنين المغناطيسي (MRI). في ظروف نادرة، يمكن استخدام أساليب التصوير هذه للمساعدة في تقييم إصابات العين أو أورامها.
العلاج
-
تحديب الصلبة
إن الأهداف الأساسية من العلاج تتمثَّل في إيقاف المرض أو تبطئة تقدمه والوقاية وتحسين واستعادة النظر. في العديد من الحالات، لا يمكن عكس الضرر الذي وقع بالفعل، لذا يعد الاكتشاف المبكر مهمًا. سيعمل طبيبك معك لتحديد أفضل علاج.
قد يكون علاج مرض الشبكية معقدًا وأحيانًا يتطلب علاجًا عاجلاً. تشمل الخيارات:
- استخدام الليزر. يمكن لجراحة الليزر إصلاح تمزق الشبكية أو الثقب الذي يصيبها. يستخدم الجراح الليزر لتسخين النقاط المحددة بالشبكية. وهذا يؤدي إلى إنشاء الندبات التي تربط (تلحم) الشبكية للأنسجة الأساسية. يمكن أن يقلل العلاج الفوري بالليزر لتمزق الشبكية الحديث فرصة تسببه في انفصال الشبكية.
- تقلُّص الأوعية الدموية غير الطبيعية. يمكن للطبيب استخدام أسلوب معروف باسم تخثير ضوئي بالليزر المشتت لتقليص الأوعية الدموية غير الطبيعية الجديدة المصابة بالنزيف أو تهدد بحدوث النزيف في العين. يمكن لهذا العلاج مساعدة المصابين باعتلال الشبكية السكري. ويمكن أن يؤدي الاستخدام المفرط لهذا العلاج إلى فقدان الرؤية الجانبية (المحيطية) أو الليلية.
- التجميد. في هذه العلامة، المعروفة باسم تثبيت الشبكية بالبرد، يضع الجراح مسبارًا للتجميد في الجدار الممتد للعين لعلاج تمزق الشبكية. يصل البرد المكثَّف إلى داخل العين ويقوم بتجميد الشبكية. تُصاب المنطقة الخاضعة للعاج بعد ذلك بالندبات وتثبيت الشبكية بجدار العين.
- حقن الهواء أو الغاز في العين. يُعرف هذا الأسلوب باسم تثبيت الشبكية الهوائي حيث يستخدمه الأطباء للمساعدة في إصلاح أنواع معينة من انفصال الشبكية. ويمكن استخدامها مع تثبيت الشبكية بالبرد أو التخثير الضوئي بالليزر.
- قطب سطح العين. تعرف هذه الجراحة باسم تحديب الصلبة حيث يستخدمها الأطباء لإصلاح انفصال الشبكية. ويقوم الجراح بتخييط قطعة صغيرة من مادة السيليكون خارج سطح العين (الصلبة). وهذا العملية تقوم بتخديد الصلبة وتخفيف بعض القوة الناتجة عن شد الجسم الزجاجي على الشبكية. ويمكن استخدام هذا الأسلوب مع علاجات أخرى.
-
تفريغ واستبدال سائل العين. في هذه العملية والتي تسمَّى استئصال الزجاجية، يقوم الجراح بإزالة السائل الأشبه بالهلام والذي يملأ داخل العين. ويحقن العين بالهواء أو الغاز أو السائل في المساحة الفارغة.
ويمكن استخدام استئصال الزجاجية إذا شكَّل النزيف أو الالتهاب سحابة على الزجاجية أو أعاق رؤية الجراح للشبكية. ويمكن أن يكون هذا الأسلوب جزءًا من علاج المصابين بمزق الشبكية أو اعتلال الشبكية السكري أو الثقب البقعي أو عدوى العين أو صدمة العين أو انفصال الشبكية.
- حقن دواء بالعين. يمكن أن يقترح الطبيب حقن دواء بالجسم الزجاجي بالعين. يمكن أن تكون هذه الطريقة فعالة في علاج الأشخاص المصابين بالتنكس البقعي الرطب أو اعتلال الشبكية السكري أو الأوعية الدموية المكسورة بالعين.
- زراعة شبكية اصطناعية. يمكن أن يكون الأشخاص الذين يعانون من فقدان حاد للرؤية أو عمى بسبب مرض في الشبكية مرشحين لإجراء جراحة. ويعرف أحد الخيارات الجراحية غير المتوفرة على نطاق واسع باسم زراعة الشبكية الاصطناعية.
التأقلم والدعم
يمكن أن يؤثر فقدان البصر الناجم عن أمراض الشبكية في قدرتك على القيام بأشياء كالقراءة، والتعرف على وجوه الأشخاص، وقيادة السيارة. قد تساعدك هذه النصائح على التأقلم مع التغيرات التي تطرأ على بصرك:
- اطلب من طبيب العيون الخاص بك فحص نظارتك. إذا كنت ترتدي العدسات اللاصقة أو النظارة، فتأكد أن الوصفة الطبية محدّثة.
- استخدم عدسات مكبرة.قد تساعدك مجموعة من الأجهزة المكبرة في القراءة والأعمال القريبة من العين مثل الخياطة. تتضمن هذه الأجهزة العدسات المحمولة باليد أو العدسات المكبرة التي ترتديها مثل النظارات. قد تستخدم أيضًا نظام الدوائر التليفزيونية المغلقة التي تستخدم كاميرا فيديو لتكبير المواد المقروءة وعرضها على شاشة فيديو.
- غير شاشة الكمبيوتر الخاصة بك وأضف أنظمة صوتية. اضبط حجم الخط وتباين الشاشة في إعدادات الكمبيوتر. فكّر في إضافة أجهزة إخراج الكلام أو غيرها من التقنيات الأخرى للكمبيوتر.
- استخدم وسائل إلكترونية تساعدك في القراءة وواجهة صوتية. جرّب ساعات اليد والساعات والحاسبات الناطقة، والكتب المطبوعة بحروف كبيرة، وأجهزة الكمبيوتر اللوحية، والكتب المسموعة. بعض الأجهزة اللوحية وتطبيقات الهواتف الذكية مصممة لمساعدة ضعاف البصر. وتأتي الكثير من هذه الأجهزة الآن مزودة بميزة التعرف على الصوت.
- اختر أجهزة خاصة مُعدة لضعاف البصر. بعض الساعات، وأجهزة الراديو والهواتف، وغيرها من الأجهزة ذات أرقام كبيرة جدًا. قد تجد أنه من الأسهل مشاهدة تلفاز بشاشة أكبر عالية الدقة أو قد ترغب في الجلوس بموضع أقرب من الشاشة.
- استخدم أضواء أكثر سطوعًا بمنزلك. تساعد الإضاءة الأفضل في القراءة وغيرها من الأنشطة اليومية، وقد تحد أيضًا من خطر السقوط.
- فكر بخيارات التنقل الخاصة بك. إذا كنت تمارس القيادة، راجع طبيبك لترى ما إذا كان من الآمن لك الاستمرار في ذلك. توخ حذرًا بالغًا في بعض المواقف، مثل القيادة ليلاً وفي مرور مزدحم أو طقس سيء. استقل النقل العام أو اطلب مساعدة صديق أو أحد أفراد العائلة. قم بتدابير لاستخدام خدمات الشاحنات المحلية أو خدمات النقل المستمرة بين مكانين متقاربين أو شبكات القيادة التطوعية أو خدمات تقاسم الركوب.
- احصل على الدعم. قد تكون الإصابة بالتنكس البقعي صعبة، وقد يتعين عليك إجراء تغييرات في حياتك. قد تختبر الكثير من المشاعر أثناء تأقلمك. ضع بالاعتبار التحدث مع استشاري أو الانضمام إلى مجموعة دعم. امض الوقت مع من يدعمونك من أفراد أسرتك وأصدقائك.
الاستعداد لموعدك
للتحقق من أمراض الشبكية، عادة ما يكون اختبار العين المتوسعة ضروريًا. قم بتحديد موعد مع طبيب متخصص في العناية بالعيون — إخصائيّ النّظّارات أو طبيب العيون. يمكنه أو يمكنها إجراء فحص كامل للعيون.
ما يمكنك فعله
قبل موعدك:
- عند تحديد موعد، اسأل إذا كنت في حاجة إلى القيام بعمل أي شيء لتكون مستعدًا.
- أعِد قائمة بالأعراض التي تعانيها، بما في ذلك تلك الأعراض التي قد لا تبدو ذات صلة بمشكلتك في الرؤية.
- أعِد قائمة بالأدوية والفيتامينات والمكملات الغذائية التي تتناولها، بما في ذلك جرعاتها.
- اطلب من أحد أفراد أسرتك أو أصدقائك مرافقتك. سيؤثر توسيع حدقتي عينيك لإجراء فحص العين على رؤيتك لفترة من الوقت بعد ذلك، لذا قد تحتاج إلى اصطحاب شخص ما للقيام بالقيادة أو لمرافقتك بعد موعد الزيارة.
- أنشئ قائمة بالأسئلة التي ستوجهها لطبيبك.
بالنسبة لمرض شبكية العين، تتضمن الأسئلة التي يجب طرحها على طبيبك ما يلي:
- ما مدى تقدّم الحالة؟
- هل من الآمن لي أن أقود؟
- هل سأعاني فقدان البصر فيما بعد؟
- هل يمكن علاج حالتي؟
- هل سيساعد تناولي الفيتامينات أو المكملات الغذائية المعدنية على الوقاية من فقدان البصر فيما بعد؟
- ما هي أفضل الطرق لمتابعة أي تغيّرات تطرأ على الرؤية لدي؟
- ما هي تغيرات الأعراض التي أعانيها التي تتطلب الاتصال بك؟
- ما هي وسائل مساعدة ضعاف البصر التي قد تكون مفيدة لي؟
- ما هي تغييرات نمط الحياة التي يمكنني إجراؤها لحماية النظر؟
ما الذي تتوقعه من طبيبك
قد يطرح طبيبك عليك عددًا من الأسئلة، مثل:
- متى لاحظت ظهور مشكلات في الرؤية لأول مرة؟
- هل يؤثر المرض على عين واحدة أم كلتا العينين؟
- هل تعاني من مشكلة في رؤية الأشياء القريبة منك، أو على مسافة، أو كليهما؟
- هل تدخن أو سبق لك التدخين ؟ وإذا كان الأمر كذلك، فما المقدار المستخدم؟
- هل تعاني مشكلات طبية أخرى، مثل ارتفاع نسبة الكوليسترول أو ارتفاع ضغط الدم أو داء السكري؟
- هل لديك تاريخ عائلي لمرض الكلى؟
- هل سبق وأصبت في عينك من قبل؟